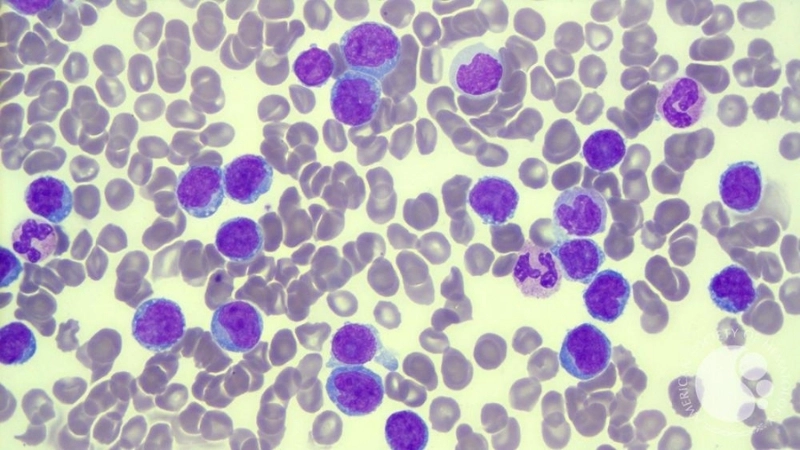
Adult T-cell Leukemia/Lymphoma seen in adult T-cell leukemia
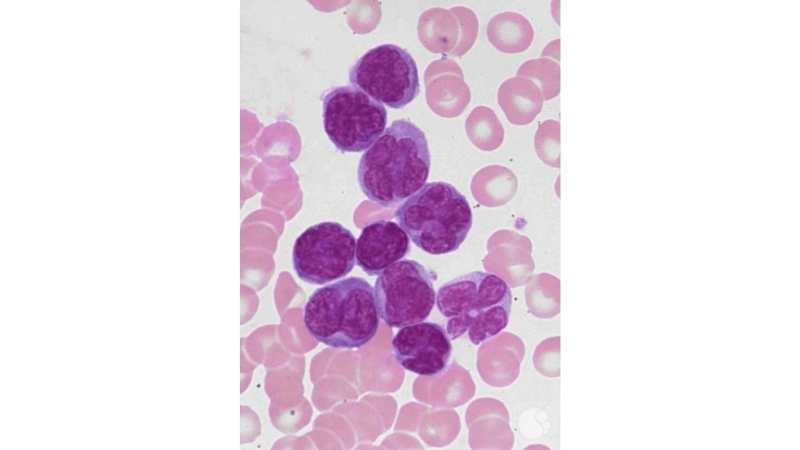
Adult T-cell Leukemia/Lymphoma confirmed with ATL diagnosis

Adult T-cell Leukemia/Lymphoma is a rare blood cancer affecting T-cells. Early detection and proper treatment are crucial for improving patient outcomes and quality of life.
What are the main causes of Adult T-cell Leukemia/Lymphoma?
- Infection with the human T-cell lymphotropic virus type 1 (HTLV-1) is the primary risk factor leading to Adult T-cell Leukemia/Lymphoma in susceptible individuals.
- Genetic mutations in T-cells can trigger uncontrolled cell growth, contributing to the development and progression of Adult T-cell Leukemia/Lymphoma.
- Long-term exposure to environmental toxins and immunosuppressive conditions may increase the likelihood of developing Adult T-cell Leukemia/Lymphoma
Key symptoms of Adult T-cell Leukemia/Lymphoma to watch for
- Persistent swollen lymph nodes in the neck, armpits, or groin are common early indicators of Adult T-cell Leukemia/Lymphoma.
- Unexplained fatigue, fever, and weight loss may signal the presence of Adult T-cell Leukemia/Lymphoma and require prompt medical attention.
- Skin abnormalities, including rashes or lesions, often appear in individuals affected by Adult T-cell Leukemia/Lymphoma.

>>>Refer to this immediately: Understanding liver cancer (hepatocellular carcinoma) risks
How can you prevent Adult T-cell Leukemia/Lymphoma effectively?
- Avoiding HTLV-1 infection through safe sexual practices and careful blood handling reduces the risk of Adult T-cell Leukemia/Lymphoma.
- Regular medical screenings and early detection of abnormal T-cell activity can help prevent severe complications of Adult T-cell Leukemia/Lymphoma.
- Maintaining a healthy immune system through balanced nutrition and minimizing exposure to toxins supports prevention of Adult T-cell Leukemia/Lymphoma.
>>>Refer to this immediately: Cervical cancer symptoms every woman should never ignore
Image description of Adult T-cell Leukemia/Lymphoma
Adult T-cell Leukemia/Lymphoma is a rare cancer affecting T-lymphocytes, a type of white blood cell. It often develops slowly and can cause swollen lymph nodes, skin lesions, and fatigue.

>>>Refer to this immediately: Understanding nasopharyngeal carcinoma causes and risks
Understanding Adult T-cell Leukemia/Lymphoma empowers patients and caregivers. Staying informed, seeking medical guidance, and accessing support resources can improve treatment success.






